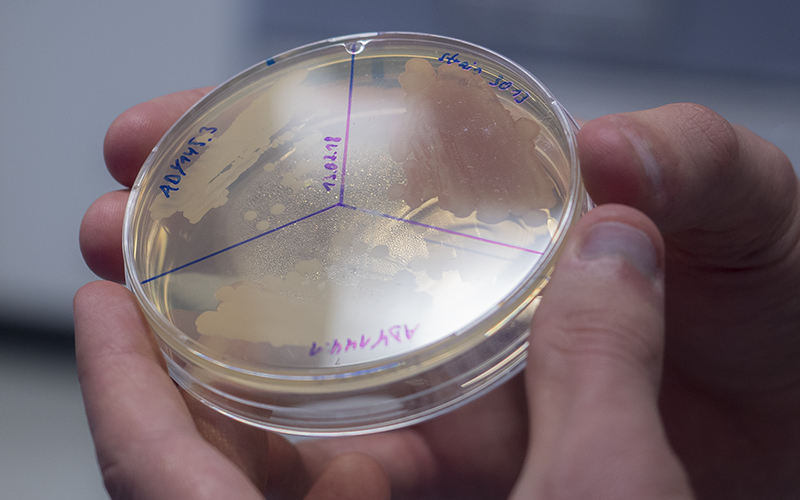

Introducing ZMB People - Alexander Dudziak
ZMB
Introducing ZMB People: Alexander Dudziak

Alexander Dudziak
PhD student, Group Stefan Westermann,
Department of Molecular Genetics I
What brings you here?
I already did my bachelor’s and master’s degree in medical biology at the University of Duisburg-Essen and I joined the lab for my master’s thesis in April 2016. When it came to the point that I needed to look and apply for PhD positions there came the opportunity to stay in this lab and to continue the work from my master’s thesis. Finally, I decided to stay in the lab because I like my project, the people, the scientific approach and I have the impression that I can learn quite a lot in this lab and its environment.
What are you currently working on?
In general, our lab investigates mechanisms of chromosome segregation. Prior to cell division the genetic information of a cell is duplicated so that two copies of each chromosome are present. These two copies need to be segregated to new emerging cells and they need to be distributed equally. Each cell needs to get one copy of each chromosome. This distribution of chromosomes is quite challenging. Movement of chromosomes is mediated by microtubules, which are polymers of tubulin proteins. These microtubules get into contact with a large protein assembly called kinetochore, located on the chromosomes. We investigate how the kinetochore gets into contact with microtubules.
In my project, I work on the so called Dam1-complex, which is a component of the outer kinetochore of budding yeast. I investigate how this complex interacts with another microtubule binding protein. In our lab we use two different approaches. The in vitro approach, meaning that we purify recombinant proteins from E. coli or insect cells and use these proteins in a simplified system. For the other approach we use Saccharomyces cerevisiae – budding yeast – in order to study protein-protein interactions in vivo. To see for example what happens if these interactions are abolished or deregulated.
What is the practical importance of your work to society?
As I said before, we use budding yeast as a model organism. At first glance, it is probably difficult to see what’s the use for – let’s say – humans. We are not really working on how mechanisms of different diseases work, but we are doing basic research. This means we investigate basic principles of cell division. Now other groups can base their work on the knowledge we generate. So, it’s a first step for further research.

What special skills are needed for your work?
There are basic skills one needs. For sure one needs to know the theoretical background of your work. One needs to know what has already been done, because this is the basis of your work. You need to be able to tolerate difficult times. If something does not work you might need to try it a second, a third, a fourth or maybe a fifth time. One needs patience.
Today many techniques are automated, so your “simply” using machines. But of course, you need to know how to handle these machines. And if data are generated automatically you still need to know how to process and interpret these results. So nowadays it’s not just pipetting and mixing reagents, but it’s also computer work.
What’s also important are social skills. It’s not like: Okay, you’re a scientist, it’s your project, you do whatever you want. No, it is also about communicating with other scientists. Either it’s discussing your results: you will get a feedback from outside and new input. So, it is helpful to talk to people from a different field, because these scientists have a different point of view. They see your problem in a different way and probably see different solutions.
What was a moment of success during your research?
Actually, I had a moment quite recently. As I mentioned before I am investigating interactions between a protein complex and another protein. So far, we knew what was roughly needed for this interaction, but the question is of course how this interaction is regulated. And recently I could find two potential proteins that might regulate or modify this interaction by phosphorylation.
And is there something that didn’t work – that drove you nuts?
Yeah, there is something I’ve been trying for – I don’t know – for a very long time. But it’s basically a very easy problem. It’s only about cloning expression constructs. I need to modify a plasmid for expression in E. coli – a process that is in most cases quite simple, but for some reason in my case it doesn’t work. I tried several different methods and so far, it’s still unsuccessful. However, it is a quite important point to get it done.

What motivates you?
What motivates me is finding out new things. Let’s say, finding out what nobody else – hopefully – discovered before. And somehow this is really exciting to me. You plan and design your experiments, and, in many cases, you have certain expectations. Sometimes your results fulfil these expectations, but often enough you are a little bit surprised. And this is what makes science and my work exciting.
What do you value here at the ZMB?
I really appreciate the ZMB, because of all the cooperation. I joined the University and the ZMB already seven years ago and in that time, I already met several different scientists and professors. And by time you get to know them, and you know who you can ask if you have a certain scientific problem. The exchange between scientists is really close. We have a close collaboration with the lab of Dominik Boos. There are also presentations about the research of other groups every Wednesday during our “lunch seminar” – one gets a good overview of what other groups are doing, which techniques they apply. This can be helpful - if you want to use their machines, it’s quite easy to get into contact with these people. A nice social aspect is that there is also a group of scientists playing football every second Tuesday. In this way you can meet people in a context outside of science and during free time activities.

What do you value in Essen or the Ruhrgebiet?
I have to say, Essen is somehow better than its reputation, at least in some parts (laughter). No – I’m actually quite happy to live in Essen. I found a nice apartment in Holsterhausen, which is a really nice area of Essen, not too far from University in the center of the city. And if I want to go outside for a walk, there are a lot of forests and parks close by. So, it’s not only a big city, but Essen has some nice green spots. The Ruhrgebiet means home to me. I grew up in Gladbeck, a neighbor town of Essen. So Ruhrgebiet is just home.
Does science influence your everyday life?
Yes! In my opinion, science is not only a job. To call it a lifestyle would be exaggerated, you don’t do it because it’s a job and you want to earn money. But you do it because you really like to do it. You might work more hours than really necessary and somehow you always take your work home. You don’t go home and leave your work here. At least in my case you cannot always stop thinking about work, you take it home. And this can sometimes be nasty, for example if you can’t find sleep. And if you observe some phenomenon at home you try to draw a scientific conclusion from that [if something grows in your fridge… take that one out].

How do you recreate in your leisure time?
I play football in a local club. We practice usually twice per week and we have a match once per week. That kind of helps me to calm down. Sometimes it’s not that easy to motivate yourself to go to practice, but if you started playing it really helps you to forget about work. The physical exercise helps you to relax. And what I also like doing when I am at home is sitting on my balcony, enjoying a rest of sunlight of the day, reading a book.
Interview, photos and video by Carola Schubert & Christian Denkhaus.
Copyright for all images and video: ZMB.
